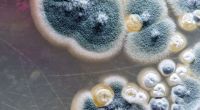

Há dois dias, a mãe do adolescente Edem Silva da Silva, morador da vila Nazaré, comunidade às margens da rodovia PA-150, procurou a delegacia de Tailândia para comunicar o desaparecimento do filho.
VEJA TAMBÉM
Carreta da Saúde leva vacinação à comunidades da zona rural em Tailândia
“Jango” morre aos 49 anos após problemas da covid-19
Laize Gomes relatou na delegacia que o filho foi visto pela última vez com uma mochila nas costas. A mulher disse ainda recebeu a informação de uma vizinha deles.
O adolescente saiu de casa, no dia 8 de junho, por volta das 9h. Quando a mãe dele retornou do serviço por volta das 16h, já não encontrou mais o garoto.
De acordo com o relato da mãe, Edem Silva esteve no início do ano, na casa da avó, no Estado do Maranhão. Laize desconfia que o garoto tenha tentado retornar para lá.